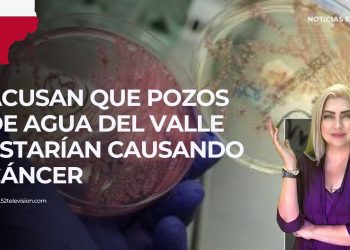
Muere la cantante tamaulipeca Dulce

Noticias
Explosión dentro de complejo químico de PEMEX
Esta y otra información en Noticias a las 9, edición México. Transmitido el 27 de diciembre del 2024. #52T #52TELEVISION...
2 heridos de bala por tiroteo en aeropuerto de Phoenix
Esta y otra información en Noticias a las 9, edición EE.UU. Transmitido el 27 de diciembre del 2024. #52T #52TELEVISION...
Asesinan a líder ganadero en Zacatecas y a otro de MORENA en Oaxaca
Esta y otra información en Noticias a las 9, edición México. Transmitido el 26 de diciembre del 2024. #52T #52TELEVISION...
Acusan que pozos de agua del Valle estarían causando cáncer
Esta y otra información en Noticias a las 9, edición EE.UU. Transmitido el 26 de diciembre del 2024. #52T #52TELEVISION...
Especial de Navidad: Navidad y Noche buena, diferentes significados
Esta y otra información en Noticias a las 9, edición México. Transmitido el 25 de diciembre del 2024. #52T #52TELEVISION...
Especial de Navidad: ¿Los regalos se abren el 23 o el 24?
Esta y otra información en Noticias a las 9, edición México. Transmitido el 24 de diciembre del 2024. #52T #52TELEVISION...
EU apoyará con 100 MDD a México para programas anti drogas
Esta y otra información en Noticias a las 9, edición México. Transmitido el 23 de diciembre del 2024. #52T #52TELEVISION...
Perdona Biden deuda estudiantil de 4 Mil MDD
Esta y otra información en Noticias a las 9, edición EE.UU. Transmitido el 23 de diciembre del 2024. #52T #52TELEVISION...
Tren impacta a camión en TX 2 fallecidos
Esta y otra información en Noticias a las 9, edición EE.UU. Transmitido el 20 de diciembre del 2024. #52T #52TELEVISION...
Alcalde agrede a mujer indígena
Esta y otra información en Noticias a las 9, edición México. Transmitido el 20 de diciembre del 2024. #52T #52TELEVISION...